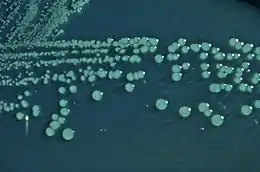

Шигельоз
Шигельо́з (лат. shigellosis; застаріле — бациля́рна дизентері́я) — інфекційна хвороба з групи кишкових антропонозів з фекально-оральним механізмом передачі, яку спричинюють бактерії з роду Shigella і яка характеризується переважним ураженням дистального відділу товстої кишки з виникненням гарячки, інтоксикаційного синдрому і діареї з домішками крові й слизу (гемоколіт).
| Шигельоз | |
|---|---|
![]() Військовополонений під час Другої світової війни — хворий на шигельоз з тяжким перебігом Військовополонений під час Другої світової війни — хворий на шигельоз з тяжким перебігом | |
| Спеціальність | інфекційні хвороби |
| Симптоми | гарячка[1], озноб[1], біль у животі[1], діарея[1][2], тенезми і наявність крові у випорожненняхd |
| Причини | Shigella, Шигела Флекснера, Shigella boydii, Шигела Зонне і Shigella dysenteriae |
| Метод діагностики | мікробіологічна культура і копроцитограма |
| Препарати | ципрофлоксацин, азитроміцин, фторхінолони, макроліди, цефтріаксон, пробіотики і дротаверин |
| Класифікація та зовнішні ресурси | |
| МКХ-11 | 1A02 |
| МКХ-10 | A03 |
| DiseasesDB | 12005 |
| MedlinePlus | 000295 |
| eMedicine | med/2112 |
| MeSH | D004405 |
Історичні відомості

Хоча початкові відомості про хворобу, що нагадує шигельоз, записані ще в єгипетському папірусі Еберса[3], однак вперше докладно описав хворобу грецький лікар Аретей Каппадокійський у І ст. до н. е. під назвою «натужний пронос». У Середньовіччя неодноразово спостерігали спустошливі епідемії дизентерії, особливо під час військових конфліктів. Через низький рівень гігієнічних умов існування у містах того часу дизентерія була однією з найчастіших хвороб. У 1891 році російський військовий прозектор О. В. Григор'єв у Варшавському військовому шпиталі з випорожнень і мезентеріальних лімфатичних вузлів, взятих від 10 вояків, померлих від дизентерії, виділив грамнегативні мікроорганізми і виказав припущення, що саме вони є збудниками цієї хвороби[4]. Однак це залишилось невідомим для більшості країн світу. Вважають, що збудника бактерійної дизентерії у 1888 р. описали французькі мікробіологи A. Шантемесс і Георг Відаль, які знайшли бактерію в кишечнику, однак вони не пов'язали її із спричиненням хвороби[5]. А в 1897 році японський мікробіолог Кіоші Шига під час значної епідемії в Японії (91 тисяча захворілих, більше 20% смертності) виділив збудника з випорожнень 37 хворих, детально описав ряд біологічних і біохімічних властивостей цих бактерій, експериментально на собаках довів, що саме цей збудник спричинює хворобу з кривавим проносом[6][7]. Таким чином, у ХIХ ст. було виявлено, що «кривавий пронос» може бути породжений амебою або бактеріями. Тому стали вирізняти відповідно амебну і бактерійну (або бацилярну за старою мікробіологічною класифікацією) дизентерію. У 1919 році Альдо Кастеллані та А. Д. Чалмерс назвали збудника бактеріальної дизентерії на честь Шига[8] й у 1951 році це було закріплено у світовому медичному просторі як рід Shigella[9]. Хворобу, таким чином, стали називати шигельозом. Було також виявлено, що існують різні види збудника шигельозу, описано ще декілька подібних мікроорганізмів: у 1906 р. — бактерії Флекснера (названі на честь Саймона Флекснера)[10][11], у 1913 р. — Зонне (названі на честь Карла Олафа Зонне[12][13], у 1936 р. — Бойда (названі на честь Марка Фредеріка Бойда)[14].
Актуальність
Нині у структурі гострих кишкових інфекційних хвороб шигельоз займає одне з чільних місць. Епідеміологічна ситуація стосовно шигельозної захворюваності залишається неблагополучною. Кожного року у світі від цієї недуги страждає до 165 млн осіб, переважна більшість — у країнах, що розвиваються, та серед дітей у віці до 5 років. Близько 1 млн помирає. Частка її у структурі розшифрованих діарей коливається від 70 до 90 %. Найбільшого поширення шигельоз набув у ряді країн Латинської Америки, Африки й Азії, де рівень захворюваності сягає 500 на 100 000 населення і є однією з основних причин смертності дітей віком до 5 років. В економічно розвинутих країнах захворюваність на шигельоз значно нижча[15].
За деякими оцінками, близько 1,1 млн чоловік, вмирають від інфекції Shigella кожен рік, причому 60% смертей припадає на дітей у віці до 5 років. Інші оцінки показують, що хворими є 90 мільйонів і відбувається 108 тис. смертей на рік. Одна з найбільших епідемій сучасності відбулася у 1999—2000 рр. на теренах Сьєрра-Леоне. За період з грудня 1999 року на кінець січня 2000 року було зафіксовано 3094 випадки шигельозу, зокрема 132 смерті[16]. Найостанньою епідемією шигельозу вважають ту, що відбулася в Судані в 2004 році. Було зафіксовано протягом червня 1340 випадків із 11 смертями[17]. Крім того, щорічно повідомляється про близько 500 тис. випадків захворювання на шигельоз серед військовослужбовців і мандрівників з промислово розвинених країн[18].
В Україні інтенсивний показник захворюваності на шигельоз коливається на рівні 30—80 на 100 000 населення. У південних і східних областях, промислово розвинутих, з високим рівнем забруднення довкілля і чисельним переважанням у демографічній структурі міського населення, хворих набагато більше, ніж у середньому по Україні.
Одного із збудників шигельозу Shigella dysenteriae віднесено до тих біологічних агентів, які офіційно визнано чинниками біологічної зброї[19].
Етіологія
? Шигела | ||||||||||||
|---|---|---|---|---|---|---|---|---|---|---|---|---|
![]() Shigella flexneri у мікропрепараті при світловій мікроскопії — червоні Грам-негативні бактерії. | ||||||||||||
| Біологічна класифікація | ||||||||||||
| ||||||||||||
Види | ||||||||||||
Посилання | ||||||||||||
| ||||||||||||
Збудником хвороби є група мікроорганізмів роду Shigella, родини Еnterobacteriaceae, що включає 4 групи і, відповідно, види:
- група А — S. dysenteriae[20], в якій розрізняють 12 самостійних сероварів, серед яких домінують 2-й і 3-й;
- група B — S. flexneri, яка нараховує 8 сероварів, домінує серовар 2а;
- група С — S. boydii, що налічує 18 сероварів, серед яких домінують 2-й і 4-й;
- група D — S. sonnei, яка має тільки один серовар, що за біохімічними властивостями поділяється на 14 варіантів і підваріантів, а по типових фагах — ще й на ряд фаготипів. У серогрупі домінують біохімічні варіанти IIe, IIg й Ia.
Культуральні властивості
Усі шигели нерухомі, у світловому мікроскопі вони виглядають як палички із закругленими кінцями, не мають джгутиків і капсули, не утворюють спор і пігменту, добре фарбуються аніліновими барвниками, грамнегативні, є факультативними анаеробами. На твердих поживних середовищах утворюють гладкі або шорсткуваті, вологі, опуклі, з рівними краями, дрібні (2 мм у діаметрі) колонії. У розвинених країнах для виділення шигел використовують так званий кишковий агар Гектоена, на якому колонії мають характерне блакитно-зелене забарвлення, або агар Оньоза чи шигельозно-сальмонельозний агар.

Шигели групи А утворюють Шига-токсин, або екзотоксин, деякі штами інших видів продукують його у значно менших кількостях. Усі шигели синтезують ще й термолабільний ендотоксин. Найменша інфікувальна доза (10—100 збудників) властива для бактерій групи А, більша (104—105) — для паличок Флекснера, найбільша (108 й більше) — для шигел Зонне.
Можливості виживання у довкіллі
Стійкість шигел тим вища, чим слабша їхня вірулентність. Так, шигели Зонне, які менш вірулентні, характеризуються значнішою стійкістю у довкіллі і меншою вибагливістю до умов культивування. Вони спроможні розмножуватися в широкому температурному діапазоні (від 10 до 45°С). На посуді й вологій білизні вони можуть зберігатися протягом місяців, у ґрунті — до 3 міс., на продуктах харчування — декілька діб, у воді — до 2 міс.; при нагріванні до 60°С гинуть через 10 хв., при кип'ятінні — негайно, у дезінфекційних розчинах — протягом декількох хвилин. Важливо, що шигели Зонне порівняно зі збудниками інших груп інтенсивніше розмножуються в молоці і молокопродуктах. Крім того, саме шигели Зонне здатні набагато довше зберігатися у цих продуктах, які часто є основними факторами передачі збудника. Це пояснюється тим, що у молоці і молочнокислих продуктах наявна багата сапрофітна мікрофлора, якій краще протидіють шигелі Зонне через їх активну коліцинопродукцію[21]. До того ж нижчі значення рН (сквашування молокопродуктів) добре переносять саме ці збудники.
Антигенні властивості
Антигенна структура шигел представлена соматичними термостабільними О-антигенами й оболонковими термолабільними К-антигенами. Вони складаються з протеїну, ліпіду А, який визначає токсигенність, й антиген-специфічного поліцукриду, що утворюють ліпополіцукридний комплекс. О-антигени досить стійкі до дії хімічних речовин. К-антигени суворо специфічні. Разом з О-антигенами вони забезпечують захист шигел від фагоцитозу. Шигели виду Зонне оболонкового антигену не мають. Антибіотикорезистентність у більшості штамів шигел детермінується плазмід-опосередкованою резистентністю (R-фактор), тобто здатна бути отримана від бактерій травної системи, а також передаватися їм.
Детальніші відомості з цієї теми ви можете знайти в статті Shigella.
Епідеміологічні особливості
Джерело і резервуар інфекції
Джерелом збудника є хворий з маніфестною або субклінічною формою недуги. Найбільшу небезпеку становлять особи із субклінічною, стертою і легкою формою хвороби, які працюють на підприємствах громадського харчування, водопостачання, у дитячих дошкільних і лікувальних закладах[22], мешкають у гуртожитках, будинках для людей літнього віку, казармах тощо, приховують недугу або не знають про те, що інфіковані. На їх частку припадає 80—90 % заражень. Шигельоз є типовим представником групи антропонозних кишкових інфекцій. Виділення шигел з фекаліями починається одночасно з першими проявами хвороби, досягає максимуму на 3—5-й день, у процесі видужання знижується, але триває аж до загоєння слизової (декілька тижнів або навіть місяців). Можливість «здорового» носійства нині підлягає сумніву. Випадки носійства шигел розглядаються як стерта і субклінічна форма хвороби. В осіб з імунодефіцитними станами (ВІЛ-інфекція, променева хвороба, аліментарна[23] дистрофія тощо) виділення шигел може тривати місяцями і часто формуються стійкі розлади функцій травної системи[24].
Механізм і фактори передачі
Механізм передачі збудників шигельозу — фекально-оральний. Поширення шигел відбувається харчовим, водним, побутовим шляхами / факторами, а також за допомогою механічних переносників — мух, які здатні переносити збудника на кінцях своїх лапок на відстань до 5 км. При шигельозі Зонне головним шляхом є харчовий, при шигельозі Флекснера й Бойда — водний, а при шигельозі, який спричинює група А шигел — побутовий шлях передачі. Не виключена можливість активації додаткових шляхів передачі (тих, що підтримують поширення інфекції на певній території, у конкретній ситуації). Також шигельоз може передаватися під час орально-анальних статевих контактів.
Сприйнятливий контингент та імунітет
Для шигельозу, спричиненому видом Зонне, характерна чітка циклічність з періодичними підйомами та зниженнями рівня захворюваності через кожні 2 роки. При шигельозі, породженому видом Флекснера, циклічності немає. Взагалі шигельозу також притаманні й сезонні зміни рівнів захворюваності: максимальний ріст відзначають у липні-серпні (шигелла Флекснера) і серпні-жовтні (шигелла Зонне). З початку 1990-х років повсюдно на території України і сусідніх держав відзначається поступова заміна збудника шигельозу з S. sonneі на S. flexnerі.
До шигельозу існує висока сприйнятливість, найбільша у дітей віком від 6 міс. до 5 років, очевидно, через функціонально-фізіологічні особливості дитячого організму і відсутність у них достатніх гігієнічних навичок. Захворюваність серед дітей у 4,3 рази вища, ніж серед дорослих. Підвищує сприйнятливість у дорослих секреторна недостатність шлунка, дисбіоз кишок, інші хронічні хвороби кишечника, а також голодування, гіповітаміноз, імунодефіцитні стани. На такому тлі шигельоз може набувати затяжного перебігу. Після перенесеної недуги формується нетривалий, суворо типо- та видоспецифічний імунітет. У захисті від повторного захворювання основну роль відіграє клітинний місцевий імунітет.
Патогенез
Ранній період
Після заковтування шигели починають розмножуватись у тонкій кишці й через 12 годин визначаються в концентрації 107−109 мікробних тіл в 1 мл інтестинальної[25] рідини. При частковому руйнуванні шигел у кишках виділяється ендотоксин, який всмоктується у кров і чинить токсичний вплив на організм. У хворого з'являються гарячка і біль у животі. Особлива білкова система шигел (так званий «комплекс III типу секреції») в тонкій кишці спричинює появу водянистих випорожнень, а ендотоксин сприяє розвитку запалення слизової оболонки і тканинної деструкції. Внаслідок дії Т-лімфоцитів кілерів через деякий час тонка кишка звільняється від бактерій і процес локалізується в товстій кишці — органі-мішені для шигел. У цей період з'являється вже колітична діарея. Ендотоксини шигел мають нейро-, ентеро- і цитотоксичну дію. Вони вибірково діють на епітелій товстої кишки, вегетативні центри і кишкові нервові сплетіння. Унаслідок цього зменшується нейтротрофічна функція вегетативних волокон, збільшується утворення слизу. Шига-токсин здатний пошкоджувати ЦНС, нефрони нирок, спричинюючи іноді гемолітико-уремічний синдром на кшталт того, що відбувається при зараженні деякими штамами О:157 кишкової палички.

Патогенетичні риси ураження товстої кишки
Шигели інвазують епітеліальні клітини кишечника. Ця властивість визначається R-фактором, пурином і лактозо-галактозною ділянкою хромосом бактерій. Концентрація шигел зменшується у напрямку від поверхневого епітелію до клітин крипт і власного шару. При інвазії слизової оболонки кишечнику зникають келихоподібні клітини й відторгається епітелій, що веде до появи поверхневих дефектів. Услід за скупченням елементів запалення розвиваються вторинні мікроабсцеси в криптах. В епітелію слизової оболонки товстої кишки шигели стають недоступними для лейкоцитів, антитіл, антибіотиків. Шигели розмножуються в цитоплазмі епітеліоцита до тих пір, поки не поглинаються його фаголізосомами. Не менш важливу роль у розвитку патологічного процесу відіграють сенсибілізація й алергічні реакції, а також нервово-рефлекторні розлади. У цей період у товстій кишці характерні дифузні катарально-ерозивні зміни слизової з численними крововиливами, у тяжких випадках виразки, фібринозні нашарування, а іноді, й вогнищеві некротичні пертурбації.
Морфологічне й функціональне відновлення кишечника істотно відстає від клінічного одужання. Повне відновлення шару слизової оболонки відбувається в тяжких випадках через 2 місяці після зникнення клінічних проявів. В окремих випадках шигельоз може мати затяжний перебіг. Хронічний перебіг шигельозу натепер більшість клініцистів не визнає, тому що існують істотні докази того, що для збудника шигельозу саме такій перебіг не притаманний.
Клінічні прояви
Класифікація
Згідно МКХ-10 виділяють у розділі «Деякі інфекційні та паразитарні хвороби», підрозділі «Кишкові інфекційні хвороби» під кодом А03 «Шигельоз», в якому додатково вирізняють:
- «Шигельоз, спричинений S. dysenterіae 1 (шигелами серогрупи А)» (А03.0),
- «Шигельоз спричинений S. flexnerі (шигелами серогрупи В)» (А03.1),
- «Шигельоз, спричинений S. boydiі (шигелами серогрупи С)» (А03.2),
- «Шигельоз. спричинений S. sonneі (шигелами серогрупи D)» (А03.3),
- «Іншій шигельоз» (А03.8),
- «Не уточнений шигельоз» (А03.9).
Розглядають в клінічному плані гострий і затяжний шигельоз, типовий і атиповий перебіг (гастроентероколітичний, гіпертоксичний, стертий, субклінічний). Інкубаційний період триває звичайно 2-3 доби. У деяких випадках він може скорочуватися до 2 годин або подовжуватися до 7-10 діб. Тяжкість хвороби (легка, середньотяжка, тяжка) визначає висота гарячки, рівень інтоксикації та частота проносу.
Типовий гострий перебіг
Найчастіше шигельоз перебігає гостро — до 3 міс. Типове захворювання починається, як правило, із загальнотоксичних симптомів, до яких дещо пізніше приєднуються ознаки ураження травної системи, у типових випадках — переважно дистального відділу товстої кишки. При цій інфекції уражені всі відділи нервової системи, що зумовлює значну частину скарг (нездужання, головний біль, запаморочення тощо) й зумовлює ряд порушень серцево-судинної (ССС) й травної систем. У хворих яскраво виражені ознаки вегетативної дистонії: почуття мерзлякуватості, тремор рук і повік, порушення дермографізму. У тяжких випадках пригнічується психіка.
Температура тіла швидко підвищується до максимальних цифр (39—40 °С і більше), утримується на постійному рівні від декількох годин до 2—5 діб і потім знижується прискореним лізисом. Остуда і піт не характерні, лише початкове підвищення температури тіла може супроводжуватися незначним ознобом. Хворі стають млявими, загальмованими, у них знижується апетит. У найближчі години від початку хвороби, значно рідше — пізніше з'являються перші симптоми ураження кишечника: хворі відчувають посилену перистальтику, що супроводжується голосним гурчанням і переливанням рідини по ходу кишечника. Виникають періодичний розлитий біль у животі й імперативні поклики на дефекацію. Невдовзі приєднується пронос. У перші години випорожнення калові, рясні, напіврідкі, часто містять слиз, з грудками неперетравленої їжі.
Колітичні прояви
У типових випадках розвивається колітичний синдром. Він проявляється переймоподібним ріжучим болем внизу живота, більше в лівій здухвинній ділянці, інтенсивність і тривалість якого залежить від тяжкості хвороби. Біль у животі звичайно передує кожній дефекації, нашаровується на неї і незабаром припиняється. Характерні тенезми (нестерпний тягнучий біль, що віддає у крижі, та відчуття печіння у прямій кишці, які виникають під час дефекації і зберігаються протягом 5—15 хвилин після неї), тривале відчуття неповного спорожнення кишечника, що створює враження незавершеності акту дефекації. Поклики до дефекації часто безрезультатні (несправжні), акт дефекації затяжний. Це зумовлено запальними змінами слизової оболонки ампулярної частини прямої кишки. При пальпації органів черевної порожнини визначають спазмовану, ущільнену й болючу товсту кишку, особливо сигмоподібній її відділ, якого промацують у вигляді тяжа. Часто пальпація посилює спазм кишечника і провокує поклики на низ. У цей час випорожнення часті, скупі, з домішками слизу і свіжої крові, а, пізніше, нерідко й гною. Спазми і нерівномірні скорочення окремих сегментів кишки призводять до затримки вмісту кишечника у верхніх його відділах (спастичні закрепи). Цим пояснюється виділення в типових і тяжких випадках недуги невеликої кількості безкалового вмісту, що складається із запального ексудату («ректальний плювок»). Незважаючи на багаторазові дефекації, часто несправжні, які можуть у тяжких випадках досягати навіть 120 разів за добу, об'єм випорожнень рідко перевищує 0,5—1 л, і тому зневоднення при типовій формі шигельозу, як правило, не настає.
Позакишкові прояви
При огляді хворого відзначають блідість і сухість шкіри, можлива гіперемія обличчя, шиї, верхньої частини тулуба. Незважаючи на гарячку, шкіра нерідко холодна на дотик, що пов'язано зі спазмом периферичних кровоносних судин і перерозподілом крові. Слизова оболонка ротової порожнини суха (внаслідок зниження слиновиділення), язик вкритий білим нашаруванням. Пульс лабільний, частий, іноді аритмічний. Артеріальний тиск (АТ) знижений. Тони серця приглушені, може прослуховуватися систолічний шум на верхівці. Органи дихання зазвичай не уражаються. Печінка й селезінка, як правило, не збільшуються. Іноді у хворих можуть виникати дизуричні явища (болюче, мимовільне сечовипускання під час тенезмів і несправжніх покликів або, навіть, затримка сечі), що виникають внаслідок порушення механізму нервової регуляції сфінктерів. Частота, глибина і тривалість вказаних змін залежать від тяжкості хвороби, а порушення окремих функцій — і від ступеня деструктивних змін у товстій кишці. При більш легких формах хвороби ступінь інтоксикації та підвищення температури менший, пронос рідший, іноді без домішок крові. Гострі явища при легкому ступені тяжкості стихають за 2-3 дні, при середній тяжкості — на 4-5-й день, дещо довше зберігаються спазм, інфільтрація і болючість товстої кишки при пальпації. Клінічне видужання настає до кінця 2-го тижня. Період розпалу при тяжкому ступеню хвороби триває до 7-10 діб, видужання настає повільно. Болючість й ущільнення товстої кишки зберігаються до 3-6 тижнів і довше.
Гастроентероколітичний варіант
Зумовлений зростаючою вагомістю харчового, переважно молочного, шляху зараження, головним чином внаслідок зараження шигелами Зонне. Цей варіант характеризується раптовим початком і бурхливим розвитком хвороби протягом 1-ї доби. У клінічній картині домінує синдром гострого гастроентериту, що перебігає з виразною інтоксикацією, а при профузній діареї й багаторазовому рясному блюванні — ще й з дегідратацією різного ступеня. Інтоксикація при гастроентероколітній формі значніша, ніж при колітичній. Хвороба починається з ознобу і підвищення температури тіла до 38-39°С, болю в надчеревній ділянці, нудоти, багаторазового блювання. Надалі виникають гурчання і біль по всьому животу, імперативні поклики на дефекацію. Випорожнення спочатку у великому об'ємі, рідкі, ясно-жовтого забарвлення з грудками неперетравленої їжі. Після зникнення діареї протягом декількох діб відзначається затримка випорожнень. При огляді хворого виявляють ознаки дегідратації помірного ступеня. Слизова оболонка ротової порожнини суха, язик, вкритий нашаруванням, сухий. Пульс частий, слабкого наповнення і напруження. АТ знижений. Тони серця приглушені, може вислуховуватися систолічний шум на верхівці. Живіт при пальпації м'який, відзначають грубе гурчання, шум плеску за ходом кишок. Тяжкість стану хворого при цьому варіанті залежить, головним чином, від ступеня дегідратації.
Гіпертоксичний перебіг
Іноді виділяють дуже тяжкий ступінь шигельозу з гіпертоксичним або блискавичним перебігом, який часто спричинюють шигели групи А з переважною дією Шига-токсину. Хворий може померти на 1-у добу від початку недуги, до появи типового колітичного синдрому. Захворювання розвивається після масивного інфікування, на тлі імунодефіцитного стану і зниженої реактивності організму. Інкубаційний період дуже короткий. Початок захворювання бурхливий, з найсильнішого ознобу, гіпертермії. Різко виражений нейротоксикоз з порушенням свідомості, розвитком сопору або глибокої коми, інфекційно-токсичного шоку (ІТШ) із синдромом дисемінованого внутрішньосудинного згортання (ДВЗ-синдромом), гострої ниркової недостатності (ГНН) і гострої надниркової недостатності. Може приєднатися менінгоенцефаліт.
Стертий перебіг
Може бути при хворобі, спричиненої будь-яким видом шигел. Виявляється в основному при цілеспрямованому опитуванні й під час проведення масових обстежень в епідемічних осередках, неблагополучних стосовно кишкових інфекцій, або в дитячих колективах. Хворі почувають себе цілком задовільно. Відзначається короткочасна дисфункція кишечнику — випорожнення кашкоподібні, без домішок слизу і крові, не більше 2-4 разів за день. Іноді турбує слабкий біль у животі. Температура тіла частіше нормальна, але може бути субфебрильною. Загальний стан хворих не порушений. Живіт при пальпації м'який, може виявлятися підвищена чутливість сигмоподібної кишки, її спазм. У випорожненнях збільшений вміст лейкоцитів, незначні домішки слизу. Часто в практиці цей перебіг фіксуюють як легкий при шигельозі.
Субклінічний перебіг
Не супроводжується інтоксикацією, дисфункцією кишок і патоморфологічними змінами слизової оболонки, однак у калі виявляють шигел. З урахуванням нових даних про чільну роль інвазії в патогенезі шигельозу повинно змінитися трактування поняття такого процесу, яке раніше називали бактеріоносійством. Людину, яка тривало виділяє шигели без клінічних ознак хвороби, потрібно розглядати як хворого на шигельоз. У таких випадках при ретельному обстеженні пацієнта виявляється, що він переносить недугу в субклінічній чи стертій формі. Таким чином, розшифровування діагнозу «здорового бактеріоносійства» залежить від застосування сучасних методів лабораторного й інструментального дослідження. Поряд із цим, можливе й так зване «реконвалесцентне бактеріоносійство», яке, однак, не є окремою формою хвороби, а вказує на те, що інфекційний процес ще повністю не завершився.
Перебіг в залежності від виду шигел
Виявлено деякі клінічні розбіжності шигельозу залежно від виду збудника. Шигельоз Флекснера характеризується переважанням середньотяжкого і тяжкого клінічного перебігу, в той час як при шигельозі Зонне їх діагностують рідше. Шигельоз Зонне більше ніж удвічі частіше, порівняно з шигельозом Флекснера, перебігає у вигляді гастроентероколітичного варіанту.
Клінічні особливості перебігу в залежності від фонових факторів
Встановлено деякі клінічні особливості шигельозу залежно від віку хворих, які полягають у тому, що з віком розвиток патологічного процесу має більш затяжний характер, що зумовлює значно триваліший період санації організму, схильність до загострень і ускладнень. У хворих похилого і старечого віку більш ніж удвічі частіше реєстрували тяжку недугу, незалежно від виду збудника. Однак ректороманоскопічне дослідження[26] у них частіше відмічають катаральні зміни слизової оболонки дистального відділу товстої кишки. Її деструкція розвивається переважно в осіб молодого віку. На тяжкість шигельозу суттєвий вплив мають супутні хронічні захворювання травної системи, органів гепатобіліарної ділянки, хвороби ССС, дихальної системи, туберкульоз, цукровий діабет, алкоголізм.
Затяжний перебіг
Характеризується збереженням клінічних ознак захворювання, запальних змін слизової оболонки товстої кишки від 1,5 до 3 міс.
Ускладнення
При тяжкому ступені хвороби у дітей, в осіб похилого і старечого віку, на фоні аліментарної й вітамінної недостатності, в алкоголіків і наркоманів може розвинутись ІТШ, дегідратаційний шок, ГНН, гемолітико-уремічний синдром, гостра недостатність надниркових залоз, пневмонія, перфорація кишки і перитоніт, інвагінація й гангрена кишки, кишкова кровотеча, шигельозний сепсис, випадіння прямої кишки тощо. До пізніх ускладнень шигельозу належать синдром Райтера та асептичні артрити, які виникають у людей із особливим локусом антигенів гістосумісності по системі HLA. Практично в усіх хворих розвивається дисбіоз кишечника.
У більшості випадків шигельоз закінчується повним видужанням. Однак останнім часом почастішали й несприятливі наслідки хвороби: постшигельозний неспеціфічний коліт, декомпенсований дисбіоз кишечника, смерть. Летальний наслідок можливий у вкрай ослаблених хворих, передусім старечого віку і немовлят.
Діагностика
Клініко-епідеміологічні засади діагностики
Клінічний діагноз шигельозу встановлюють за допомогою комплексу клінічних та епідеміологічних методів:
- вживання підозрілого на зараження/контамінацію збудником продукту, перебування пацієнта в епідемічному осередку, можливий контакт із хворим, незадовільні умови побуту, що сприяють реалізації фекально-орального механізму передачі збудника;
- гострий початок, нерідко з остуди, поява гарячки;
- відповідність ступеня інтоксикації висоті гарячки;
- біль у животі, переважно у лівій здухвинній ділянці або розлитий біль.
- тенезми і несправжні поклики на низ;
- болючість й ущільнення сигмоподібної кишки;
- домішки слизу і крові у випорожненнях;
- часті мізерні випорожнення, що набувають характеру «ректального плювка»;
Загальнолабораторна діагностика
У периферичній крові виявляють лейкоцитоз, нейтрофільоз, певне підвищення ШОЕ. Виразність цих змін корелює із ступенем тяжкості хвороби. При тяжкому перебігу в сечі відзначають протеїнурію, циліндрурію.

Суттєву допомогу надає копроцитограма. Мікроскопічне дослідження випорожнень вказує на велику кількість нейтрофільних лейкоцитів, еритроцитів, слизу. Заслуговує на увагу визначення в калі маркера нейтрофілів — лактоферину.
Інструментальна діагностика
Діагностичну цінність має ректороманоскопія або сигмоїдоскопія, в тому числі, й ендоскопічна, нижніх відділів кишечника. У типових випадках вона, зазвичай, недоцільна. Але має суттєве підкріплення для діагностиці стертого або субклінічного перебігу, при проведенні диференційної діагностики у випадках відсутності ефекту від адекватної антибактеріальної терапії. Вона обов'язково проводиться в реконвалесценції шигельозу всім представникам декретованих груп. Виявлення катарально-ерозивних, виразкових змін слизової свідчить на користь проктосигмоїдиту і дає певну підтримку лікарю в клініко-патогенетичному обґрунтуванні шигельозу. У складних випадках за допомогою цього методу є можливим взяття мазка безпосередньо з ерозій чи виразок з подальшим посівом на штучні поживні середовища. За необхідності можливе й отримання біоптату.
Специфічна діагностика
Зазвичай ґрунтується на бактеріологічному виділенні збудника з випорожнень (рідше з блювотиння, промивних вод шлунка тощо) та його родовій і видовій ідентифікації. Посів проводять в Україні на поживні середовища Ендо, Плоскірева. З метою діагностики використовують серологічні реакції з парними сироватками (реакція непрямої гемаглютинації — РНГА, рідше реакція аглютинації). Діагностично значущим є як мінімум чотириразове наростання їх титрів. Натепер для підтвердження діагнозу, крім класичних бактеріологічних й серологічних тестів, усе більшого практичного значення набуває використання ІФА, РІФ, радіоімунного методу, імуноблотингу, імуносорбційних методів експрес-діагностики, ПЛР. Дуже перспективним є поєднане застосування ІФА і ПЛР.
Негативні результати бактеріологічного і серологічних досліджень не виключають можливості діагностики шигельозу клініко-епідеміологічно.
Лікування
Загальні заходи
Лікування хворих на шигельоз залежно від клінічних та епідеміологічних показань здійснюють удома чи в стаціонарі.
Клінічними показаннями до госпіталізації хворих є:
- тяжкий і середньотяжкий ступінь хвороби,
- наявність обтяжливої супутньої недуги,
- затяжний перебіг шигельозу,
- вік (до 3 років, похилий і старечий).
Епідеміологічні показання:
- відсутність удома умов для здійснення протиепідемічного режиму;
- коли сам хворий або члени його сім'ї є працівниками закладів громадського харчування чи до них прирівнюються;
- проживання з дітьми, які відвідують дошкільні дитячі заклади;
- проживання в гуртожитку.
Дорослих і дітей старшого віку можна лікувати в домашніх умовах з дозволу санітарно-епідеміологічної служби, якщо будуть забезпечені регулярне спостереження сімейного чи дільничного лікаря і протиепідемічний режим.
Хворі на шигельоз тяжкого ступеня потребують ліжкового режиму. Після поліпшення їх стану руховий режим розширюють. Одним з основних складників комплексної терапії є дієта. У гострий період призначають дієтотерапію — стіл № 4 за Певзнером. Хворим доводиться цілком відмовитися від продуктів, що містять лактозу, враховуючи те, що у більшості з них розвивається певна дисахаридазна недостатність.
Етіотропна терапія
Є головним напрямком лікування. Вона не показана лише хворим із субклінічним та стертим перебігом. Експерти ВООЗ на даний момент рекомендують у дорослих при середньотяжкому та тяжкому перебігу ципрофлоксацин по 0,5 г 2 рази на добу перорально або інші фторхінолони нереспіраторного призначення, або азитроміцин 0,5 1 раз на добу перорально. При гіпертоксичному перебігу, у вкрай ослаблених хворих допустиме призначення цефтріаксону 1,0—2,0 г 1 раз на добу внутрішньовенно (в/в) протягом 5 днів.
Тривалість курсу етіотропної терапії при середньому ступені тяжкості шигельозу, як правило, не повинна перевищувати 2—3 доби, а при тяжкій формі — 4—5 діб. Натепер фахівці ВООЗ вважають такі препарати, що широко використовувались раніше, як ампіцилін, левоміцетин, тетрациклін, налідиксова кислота, сульфаметоксазол+триметоприм абсолютно непридатними для лікування шигельоз через широко поширену в світі стійкість шигел до цих препаратів. Так само експерти ВООЗ вважать недоцільними використання нітрофуранів, аміноглікозидів, цефалоспоринів 1 та 2-ї генерації, амоксициліну через погане проникнення їх до слизової товстої кишки.
Незначна дисфункція кишок у ранній реконвалесценції не є показанням до продовження антибіотикотерапії. Розвиток шигельозного процесу в кишечнику призводить до порушень якісного і кількісного складу нормальної мікрофлори. Ці зміни наростають при лікуванні антибактерійними препаратами. Тому при легкому ступеню шигельозу, по закінченню курсу антибіотиків потрібно використовувати пробіотики з вмістом лактобактерій.
Патогенетична терапія
З урахуванням клінічних показань призначають дезінтоксикаційну, в тому числі, в тяжких випадках, й ентеросорбцію, регідратаційну терапію та інші види патогенетичного лікування.
Для корекції травної функції використовують ферментні засоби, особливо хворим із супутніми хворобами органів травлення. Вибір ферментного препарату повинен ґрунтуватися на конкретних клінічних показаннях і даних лабораторного обстеження.
Реконвалесцентам не рекомендують споживати свіже молоко, жирну їжу, гострі страви, а також будь-які алкогольні напої протягом найближчих 1-2 міс. Весь цей час доцільно застосовувати пробіотики.
Профілактика
Передбачає здійснення класичних санітарно-гігієнічних, протиепідемічних заходів, спрямованих на розрив механізму передачі збудника, на всі ланки епідемічного процесу. З метою виявлення джерела, шляхів і факторів передачі збудника вивчають особливості харчування, водопостачання, побутові та інші умови, що могли сприяти появі шигельозу. Профілактичні заходи повинні охоплювати як окремих осіб, так і колективи. Вельми важливо ретельно дотримуватися правил особистої гігієни, зокрема миття рук після дефекації. Інфіковані особи не повинні брати участь в приготуванні їжі, слід проводити відповідну дезінфекцію туалетів.
Для нейтралізації джерела збудника вдаються до таких заходів:
- виявлення та ізоляція хворих (їх госпіталізують за наявності відповідних клінічних і епідеміологічних показань);
- встановлення спостереження за контактними в епідемічному осередку протягом 7 діб від часу ізоляції останнього хворого (здійснюють контроль за випорожненнями, а в дітей — ще й термометрію);
- одноразове бактеріологічне обстеження (у квартирних осередках) декретованих працівників і організованих дітей, а в разі позитивного результату — також інших членів колективу;
- припинення ізоляції не раніше ніж через 3 дні після клінічного одужання і (для декретованих і прирівняних до них осіб) негативного результату бактеріологічного дослідження калу, яке здійснюють через 2 доби після завершення антибактерійної терапії.
Важливим є знезаражування виділень хворих за допомогою дезінфекційних засобів. Оскільки після перенесеного шигельозу можливе формування постшигельозного коліту й дисбіозу, встановлюють диспансерне спостереження за реконвалесцентами протягом 3 міс., а за наявності показань — і довше. Хвороба не є вакцинокерованою, ефективних вакцин, здатних спричнити тривалий імунітет, на сьогодні ще не розроблено.
Див. також
Примітки
- WikiSkripta — 2008. — ISSN 1804-6517
- Disease Ontology — 2016.
- Середина XVI ст. до н. е.
- А. В. Григорьев. К вопросу о микроорганизмах при дизентерии. Военно-медицинский журнал, 1891, июль, стр. 73-102. (рос.)
- Sur les microbes de la dysentérie épidémique. Bulletin de l'Académie de médecine, Paris, 1888, 19: 522–529.
- Shiga, K. Jeber den Dysenterie bacillus (Bacillus dysenteriae). Zent. f. Bakt. 1.Abt. 24:817-828,. 870–874. 912–918. 1898.
- Shiga, K. (1898), «Ueber den Erreger der Dysenterie in Japan», Zentralbl Bakteriol Mikrobiol Hyg (Vorläufige Mitteilung) 23: 599–699.
- Castellani, Aldo and Albert J. Chalmers Alanual of Tropical Medicine Ed.3, 1919.
- Shigellа Commission. Nomenclature and Classification of the Dysentery Bacilli. Int. Bact. Nomenclature and Taxonomy. 1: 159–157. 1951.
- Flexner, Simon. On the Etiology of Tropical Dysentery. Philadelphia Medical Journ. 6:414. 1900.
- Flexner, Simon. Studies of the Rockefeller Inst. Med. Res. 2:12. 1904.
- Whonamedit? A dictionary of medical eponyms Carl Olaf Sonne
- Sonne, Carl Olaf Giftfattige dysenteribaciller [manuscript]: experimentelle og kliniske studier. Kjøbenhavn: A. Busck, 1913. 229 p.
- Whonamedit? A dictionary of medical eponyms Mark Frederick Boyd
- М. А. Андрейчин Шигельоз /Здоров'я України, лютий 2007 р., № 2/1, — С. 50-51.
- 2000 — Dysentery in Sierra Leone. 24 January 2000
- Shigellosis in Sudan. 14 July 2004
- World Health Organization. Diarrhoeal Diseases (Updated February 2009).
- Список товарів подвійного використання, що можуть бути використані у створенні бактеріологічної (біологічної) та токсинної зброї, затверджений постановою Кабінету Міністрів України від 28.01.2004 р. № 86 (у редакції постанови Кабінету Міністрів України від 05.04.2012)
- Раніше в СРСР їх називали «шигели Григорьєва-Шига».
- Вироблення речовин білкової природи, що вбивають інші бактерії того ж або близьких видів.
- Так звані декретовані з точки зору епідеміології групи працюючих
- Пов'язана з порушенням травлення або нестачею харчових продуктів.
- Тварини в природних умовах не хворіють на шигельоз, навіть людиноподібні мавпи. У лабораторних умовах можливо заразити деяких тварин експериментальними шляхами. Класичним є зараження шигелами кролів під кон'юнктиву.
- Такої, що міститься у просвіті кишечника.
- Інструментальний огляд прямої і сигмоподібної кишок через анус.
Джерела
- Інфекційні хвороби (підручник) (за ред. О. А. Голубовської). — Київ: ВСВ «Медицина» (2 видання, доповнене і перероблене). — 2018. — 688 С. + 12 с. кольор. вкл. (О. А. Голубовська, М. А. Андрейчин, А. В. Шкурба та ін.) ISBN 978-617-505-675-2 / С. 78-87
- Возіанова Ж. І. Інфекційні і паразитарні хвороби: В 3 т. — К.:"Здоров'я",2008. — Т.1.; 2-е вид., перероб. і доп. — 884 с. ISBN 978-966-463-012-9
- Joyann A Kroser, Amandeep Singh Shigellosis. Medscape/Gastroenterology Sections/Colon. Specialty Editor Board Ronnie Fass. Updated: Dec 18, 2014 (англ.)
- World Health Organization. Guidelines for the control of shigellosis, including epidemics due to Shigella dysenteriae type 1. Printed by the WHO Document Production Services, Geneva, Switzerland. 2005. ISBN 92 4 159233 0 NLM Classification: WC 282 (англ.)
- Андрейчин М. А., Козько В. М., Копча В. С. Шигельоз. — Тернопіль: Укрмедкнига, 2002. — 362 с.
- Падалка Б. Я. — Дизентерия. Госмедиздат УССР. — 1955. — 176 с. (рос.)

